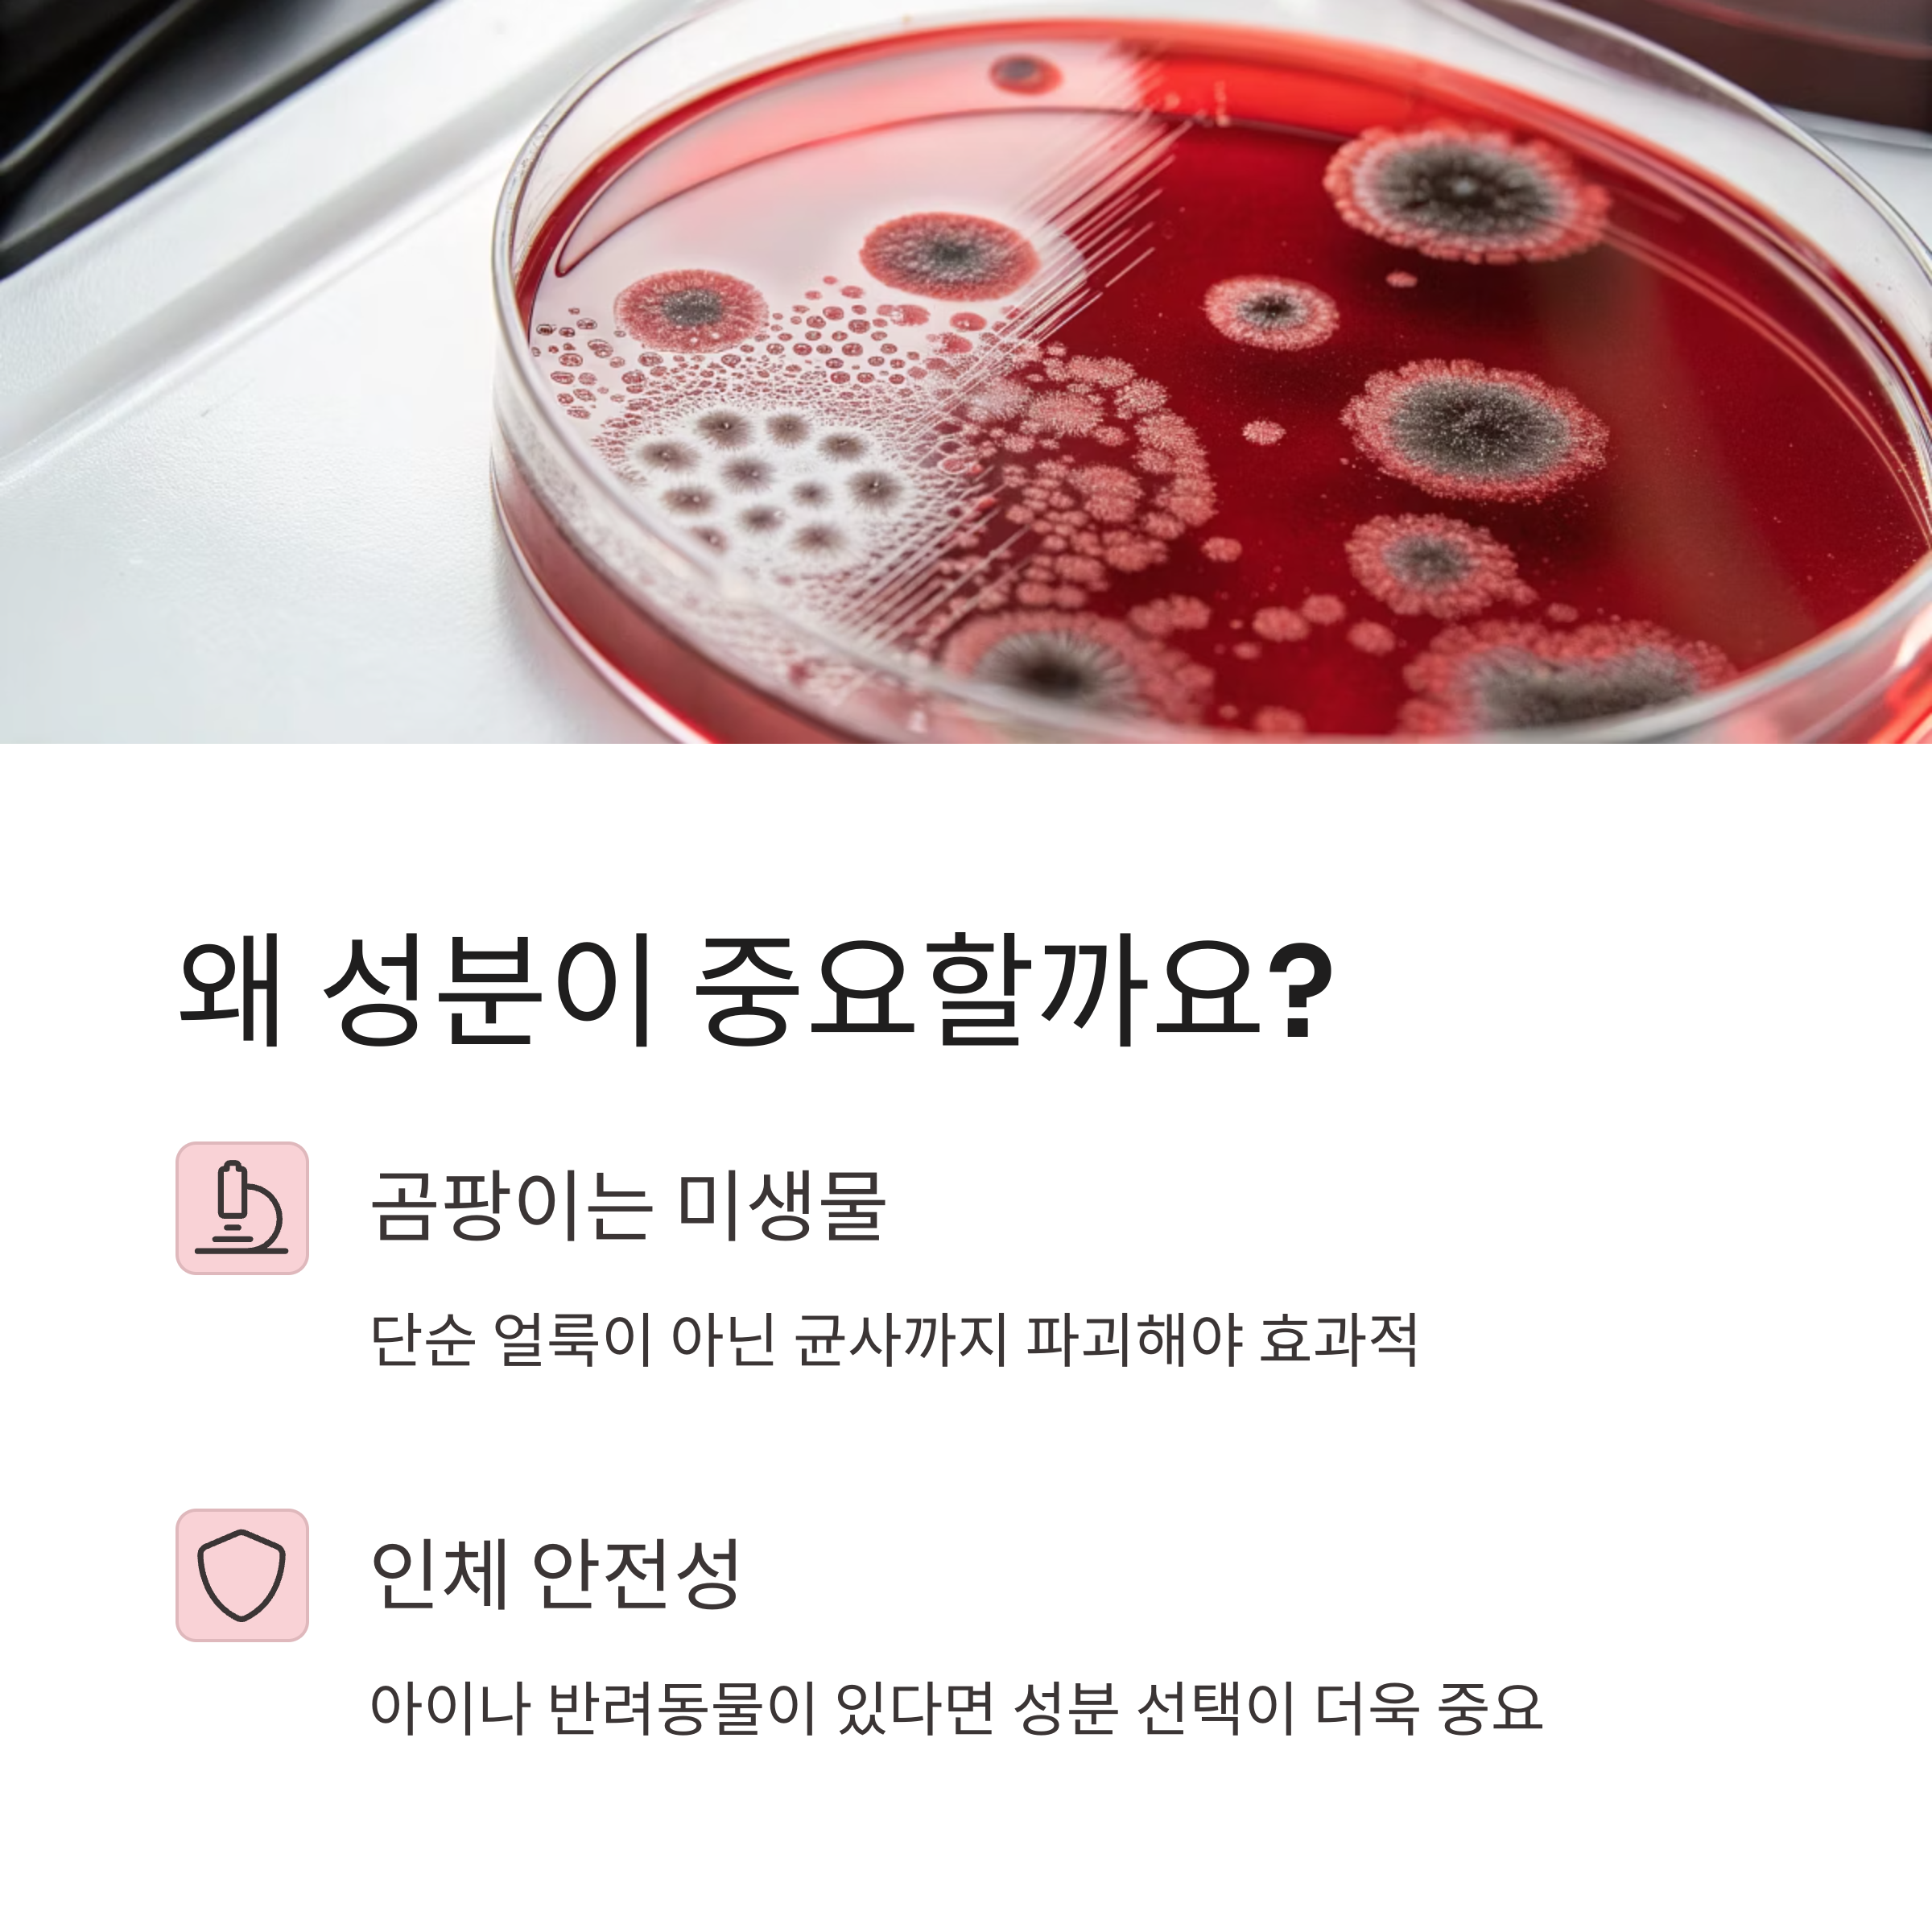

곰팡이 제거제, 아무거나 뿌리면 다 되는 줄 아셨나요? 제거 성분에 따라 효과, 지속력, 안전성까지 확연히 달라집니다.
안녕하세요! 욕실, 창문틀, 벽지, 실리콘 틈 사이에 피어나는 곰팡이 때문에 스트레스받아보신 적 있으시죠? 저도 과거엔 ‘락스 뿌리면 다 되겠지’라는 생각으로 사용했는데요, 결과는? 일시적 제거는 됐지만 자극적인 냄새와 다시 피어나는 곰팡이에 지치기만 했죠. 그런데 곰팡이 제거제는 단순히 락스만 있는 게 아니더라고요. 염소계, 과산화수소, 천연 성분, 산소계 등 성분에 따라 제거 효과와 사용 목적이 완전히 다릅니다. 오늘은 ‘곰팡이 제거제 성분별 차이점’을 중심으로, 가장 효과적인 선택 방법을 정리해 드릴게요. 곰팡이 세정제 종류 비교, 안전한 곰팡이 제거 방법, 곰팡이 냄새 제거까지 롱테일 키워드로 꼭 필요한 정보만 담았으니 끝까지 함께해 주세요!
목차
곰팡이 제거제, 왜 성분이 중요할까?
곰팡이 제거제를 선택할 때 가장 먼저 살펴야 할 것은 ‘얼마나 잘 닦이냐’가 아니라 ‘무엇이 들어 있는가’입니다. 왜냐하면 곰팡이는 단순한 얼룩이 아니라 미생물의 일종으로, 성분에 따라 곰팡이의 균사까지 파괴할 수 있는지 여부가 결정되기 때문이에요. 또한, 제거제의 성분은 인체 독성과도 직결됩니다. 아이가 있거나 반려동물이 있는 집이라면, 강력한 화학성분보다 안전한 대안을 선택하는 것이 중요하죠.
염소계 제거제 – 즉각 효과 vs 강한 자극
염소계 제거제는 흔히 ‘락스’로 알려진 차아염소산나트륨(NaClO)이 주성분입니다. 곰팡이의 색소를 탈색시키고 균사까지 파괴할 수 있는 가장 강력한 살균/표백 작용을 지녔죠. 빠른 시간 내에 눈에 띄는 제거 효과를 원할 때 적합하며, 욕실 실리콘, 타일 줄눈 등 곰팡이가 짙게 낀 부위에 자주 쓰입니다.
| 장점 | 단점 |
|---|---|
| 빠른 효과, 넓은 범위 사용 가능 | 강한 냄새, 인체 자극, 탈색 위험 |
| 균사까지 파괴해 재발 방지 | 환기 필수, 금속 부식 가능 |
과산화수소계 제거제 – 인체에 비교적 안전한 대안
과산화수소(H₂O₂)는 살균·탈취 기능이 뛰어난 산소계 표백제로, 염소계 제품보다 냄새나 자극이 훨씬 덜합니다. 특히 아기용품이나 주방, 세탁기 내부처럼 인체와 가까운 공간에 사용하기 적합하죠. 곰팡이 제거는 물론이고 냄새까지 줄여주며, 표면 탈색이 거의 없다는 것도 장점입니다.
- 천, 플라스틱에도 안전하게 사용 가능
- 잔류 독성 없음, 자연 분해됨
- 효과는 염소계보다 느릴 수 있음

천연/식물성 성분 – 안전하지만 한계도 있다
요즘은 친환경 생활을 추구하는 분들을 위해 식물 추출물 기반의 곰팡이 제거제도 많이 출시되고 있어요. 티트리 오일, 레몬 추출물, 자몽씨 등 항균 작용이 있는 천연 성분을 활용한 제품들인데요, 인체에 무해하고 자극이 거의 없어 아이가 있는 가정이나 임산부가 사용하는 공간에도 적합합니다.
하지만 곰팡이 제거력 자체는 다소 약할 수 있어 초기 상태의 곰팡이나 예방용으로 활용하는 것이 좋고, 이미 심하게 번진 곰팡이에는 효과가 떨어질 수 있습니다. 그래서 보통은 주 1~2회 정기 관리 용도로 추천돼요.
용도별 곰팡이 제거제 성분 비교표
| 구분 | 주요 성분 | 추천 용도 | 주의사항 |
|---|---|---|---|
| 염소계 | 차아염소산나트륨 | 욕실, 실리콘 틈 | 자극 강함, 환기 필수 |
| 과산화수소계 | 과산화수소 | 주방, 아기용품 | 직사광선 피하기 |
| 천연성분 | 티트리, 레몬, 자몽씨 등 | 욕실 예방, 가벼운 곰팡이 | 심한 오염엔 효과 약함 |
내 환경에 맞는 제품 고르는 3가지 기준
- 사용 장소 – 실리콘 틈? 주방? 장소에 따라 성분을 달리 선택하세요.
- 자극 여부 – 민감한 분, 아이가 있다면 과산화수소계나 천연 제품이 좋아요.
- 오염 정도 – 곰팡이가 심하다면 염소계로 빠르게 제거 후 관리 제품을 병행하세요.

네, 과산화수소나 산소계 표백제도 곰팡이 제거에 효과가 있습니다. 냄새가 덜하고 자극도 적어서 예민한 공간에 적합해요.
아니요, 곰팡이 제거는 일시적 해결일 수 있습니다. 통풍, 습도 관리, 예방 코팅 등 사후 관리까지 병행해야 재발을 막을 수 있어요.
일정 부분은 가능하지만, 심한 곰팡이 냄새 제거엔 한계가 있습니다. 초기 상태에서 사용하는 것이 효과적이에요.
절대 안 됩니다. 특히 염소계와 산소계, 또는 산성·염기성 제품을 섞으면 유해가스를 유발할 수 있어 매우 위험합니다.
제품마다 차이가 있지만, 보통 15~30분 정도 방치 후 닦아내는 것이 좋습니다. 설명서를 꼭 확인하고 사용하세요.
네, 곰팡이를 깨끗이 제거한 후 완전히 건조시킨 다음 곰팡이 방지 코팅제를 바르면 더 오래 효과를 유지할 수 있습니다.

곰팡이 제거제는 단순히 얼룩을 없애는 세제가 아니라, 공간의 위생과 가족의 건강을 지키는 중요한 도구입니다. 오늘 소개한 성분별 차이점을 참고하셔서, 우리 집 환경에 가장 잘 맞는 제품을 선택해 보세요. 즉각적인 효과가 필요한지, 자극 없는 안전함이 중요한지에 따라 선택도 달라지니까요. 곰팡이와의 싸움에서 현명한 선택으로 승리하시길 바랍니다! 사용해 보신 제품이 있다면 댓글로 추천도 함께 나눠주세요.
이전 발행글 보기
매번 곰팡이 청소 지치셨나요? 욕실 곰팡이를 막는 5가지 생활습관
샤워 후에도 욕실에서 퀴퀴한 냄새가 가시지 않나요? 벽 틈이나 실리콘 사이에 자꾸 생기는 곰팡이… 사실 미리 막을 수 있습니다.안녕하세요, 여러분! 저도 한때 욕실 곰팡이와의 전쟁에 매일
well.lovemylifejk.com
지하실 습기 잡는 5가지 제습기 비교! 최고의 선택은?
지하실 냄새, 곰팡이, 눅눅한 공기… 해결 못하고 방치하고 계셨다면? 지금이 바로 지하용 제습기를 제대로 고를 때입니다.안녕하세요! 여러분도 지하실 특유의 눅눅한 공기에 한 번쯤 스트레스
well.lovemylifejk.com
제습기 가격 비교만 하시나요? 진짜 중요한 1가지 기준
비 오는 날, 집안이 꿉꿉하고 빨래는 안 마르고… 제습기만 있으면 다 해결될 것 같죠? 하지만 아무 제습기나 사면 후회할 수도 있습니다.안녕하세요! 요즘처럼 장마철이나 여름철 습기가 많은
well.lovemylifejk.com
실내 공기질이 걱정되시나요? 공기 정화에
"아무리 환기해도 집 안 공기가 답답하다" 느끼신 적 있나요? 자연스럽게 실내 공기질을 개선해주는 식물들, 알고 보면 우리 곁에 쉽게 둘 수 있답니다.안녕하세요, 여러분! 저는 요즘 미세먼지
well.lovemylifejk.com
답답한 실내공기? 공기질 개선에 탁월한 식물 5가지
공기청정기만으론 부족하다고 느끼셨나요? 실내 공기질을 자연스럽게 개선해주는 식물 5가지를 소개합니다. 우리 집이 마치 숲속처럼 맑아질 수 있어요.안녕하세요! 요즘 미세먼지나 포름알데
well.lovemylifejk.com